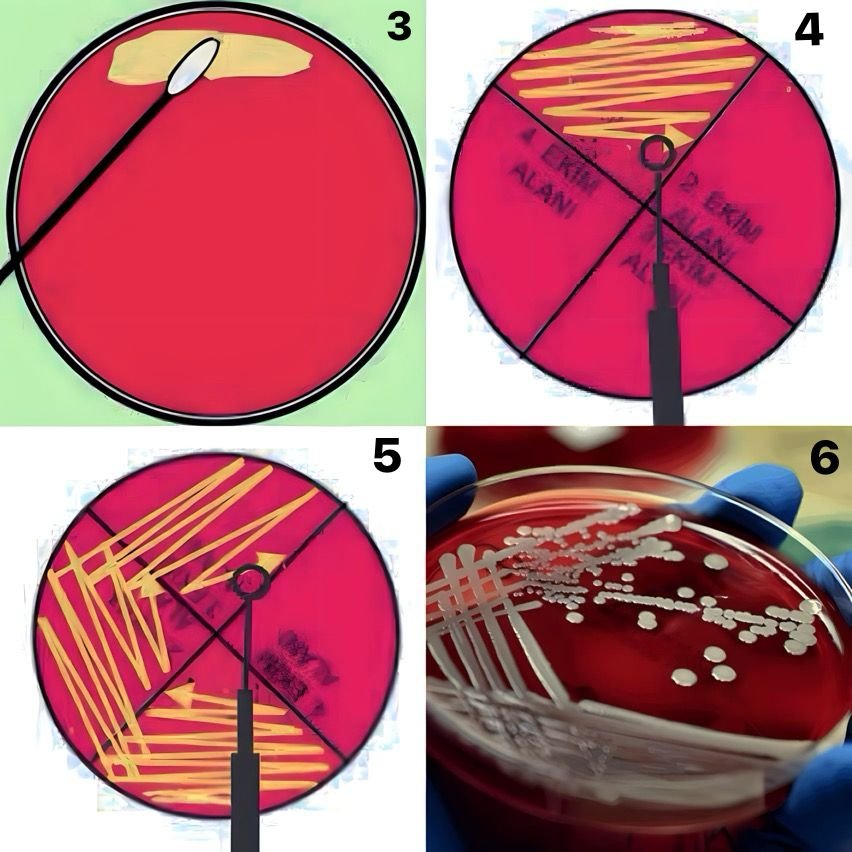
Mikroskopta Bakteri Macerası: Kendi Örneklerinizi Nasıl Hazırlar ve İncelersiniz?

Mikroskopta Bakteri İnceleme Yöntemleri
Mikroskopta bakteri incelemek için öncelikle bakteri örneklerini nereden alacağımızı ve nasıl hazırlayacağımızı bilmemiz gerekir. Bu yazıda, kendi elimizden veya yüzümüzden alabileceğimiz bakteri örneklerinin mikroskopta nasıl görüntülenebileceğini ve Gram boyama yöntemi ile bakterilerin Gram özelliğinin nasıl belirlenebileceğini anlatacağız.

Bakteri Örneklerinin Alınması ve Hazırlanması
Mikroskopta; saç teli, kan, tükürük, tırnak gibi insana ait birçok numune incelenebilir. Bu numunelerin göz ile görülebilmesinden dolayı makroskobik incelemesi mümkündür. Peki ya gözle göremeyeceğimiz, mikroskopta görünen, renkli görüntülerdeki bakterileri nereden elde edeceğiz?
En zararsız yöntem ile kendi elimizden/yüzümüzden alabileceğimiz örnekler için bazı laboratuvar malzemelerine ihtiyacımız olacak. Deney için lazım olan malzemeler şunlardır:
- Kanlı Agar (Plate)
- Steril Swap
- Lam
- Steril Öze
- Gram Boyama Seti
- 37°C’de çalışan Fırın (Etüv)
- Bunsen Beki / İspirto Ocağı (Tüm çalışma ateş'in yanında yapılmalıdır)
Hazırlama süreci ise şu şekilde:
- İlk olarak elimizden ve parmak uçlarımızdan (parmak uçları daha fazla temasta bulunur. Bu nedenle en çok mikroorganizma parmak uçlarında bulunur.) ıslattığımız Steril Swap ile döndürerek ve bastırarak (örneğin swap’ın her yerine iyice temas edebilmesi için döndürmek ve bastırmak önemli) örneği hazırlayalım. Swap’ın ucunu başka bir yere değdirmemeye özen gösterelim.
- Swap’da bulunan örneği plate’e döndürerek ve bastırarak (Swap’ın üzerinde bulunan mikroorganizmalar’ın agar’ın her yerine temas etmesi önemli) (1,3 görsel) bırakalım.

- Swap ile bıraktığımız örneği öze ile (2,4 görsel) plate’te azaltarak ekim yöntemi ile (bu yöntem, bakterileri tek koloni haline düşürmek için kullanılır.) 4 (5. görsel) bölge’ye yayıyoruz. Ekim işlemi bittikten sonra plate’i 37°C’de etüv’e(24-48 saat) kaldırıyoruz.

- 24-48 saat sonra etüv’den plate’i çıkardığımızda 6. görseldeki gibi bir görüntü elde ederiz.
- Bir adet lam alıp üzerine öze ile az miktarda su bırakalım.
- 6. görseldeki gibi görünen platede, tek düşmüş koloniden öze ile az miktarda bakteriden alıyoruz. (Tek bir kolonide Milyonlarca bakteri bulunur. Bu nedenle az miktarda almak önemli bir hususdur. Mikroskop’da daha az yoğun bir ortam görmemizi yani bakteri'nin morfolojisini daha net görebilmemize yardımcı olur.
- Öze’nin ucundaki bakteriyi lam’a bırakıp (7. görsel) su ile birlikte lam’a yayalım. (8. 10. görseller)

- Havada kurutulup ateş ile tespit (lam, bakteri yayılan kısım üstte kalacak şekilde 3 kere ateşten geçirilir) edilir.
Gram Boyama Yöntemi Nedir? Nasıl Yapılır?
Bakteriler Gram özelliğine göre 2’ye ayrılmaktadır: Gram (-) Negatif ve Gram (+) Pozitif. Gram özelliğini belirlemek için ise Gram Boyama yöntemi kullanılır. Her boyama aşaması sonrasında lam, su ile yıkanır. Sırası ile şu boyalar kullanılır:
- Kristal Viyole (2 dakika beklenir)
- Lugol (1 dakika beklenir)
- Alkol (15 sn beklenir)
- Fuksin (Safranin) (1 dakika beklenir)

Boyama işlemi bitip preperat kuruduktan sonra Işık mikroskobunda 100x’de (İmmersiyon objektifi) incelenir. Görüntüler ise aşağıdaki gibidir: (Mor renk pozitif, pembe renk ise negatif anlamına gelmektedir) Mikroskop Kullanımı için: Işık Mikroskopu nasıl kullanılır? yazımıza göz atabilirsiniz.